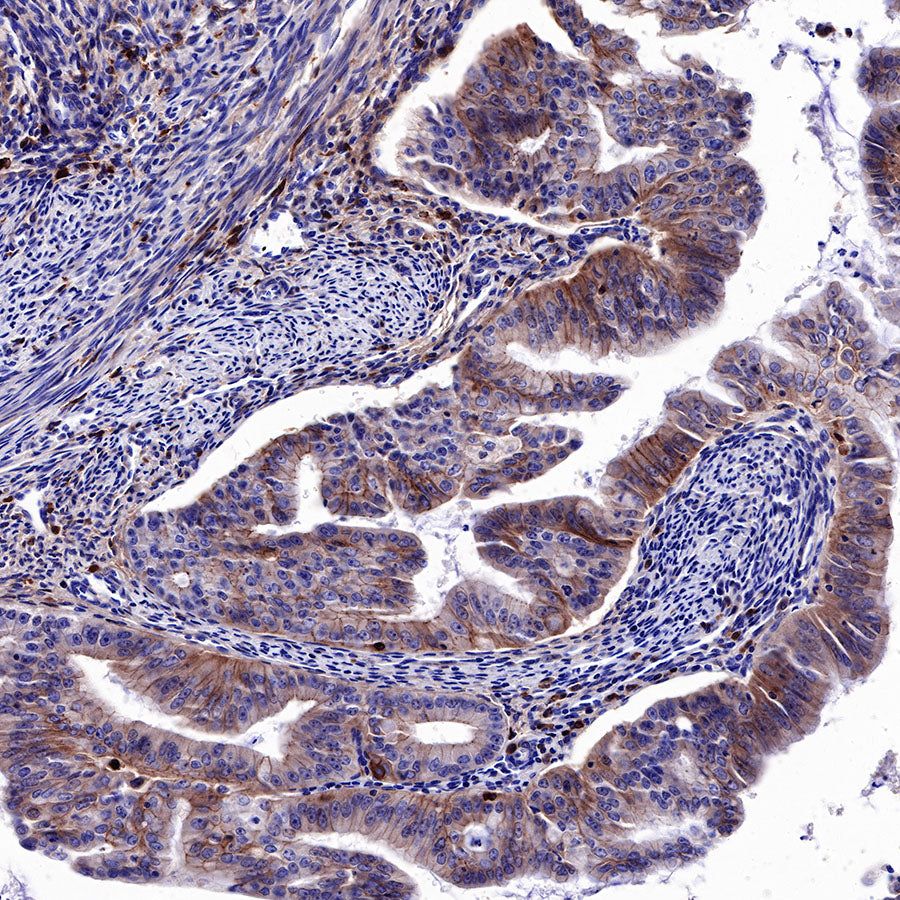
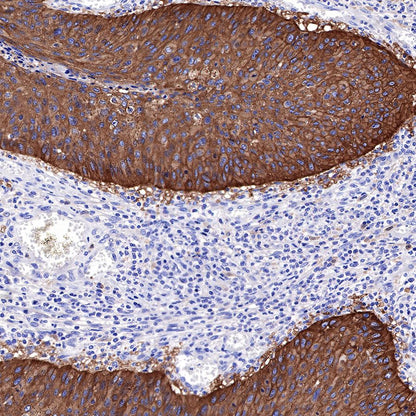
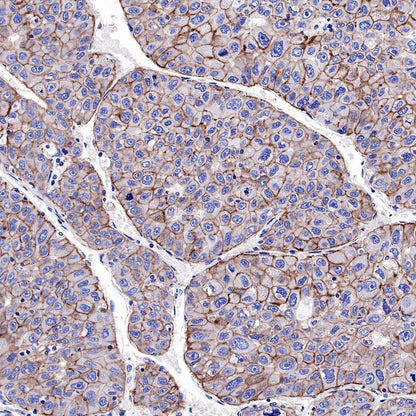

WB result of EGFR Rabbit mAb
Primary antibody: EGFR Rabbit mAb at 1/1000 dilution
Lane 1: HeLa whole cell lysate 20 µg
Secondary antibody: Goat Anti-Rabbit IgG, (H+L), HRP conjugated at 1/10000 dilution
Predicted MW: 134 kDa
Observed MW: 175 kDa
Product Details
Product Details
Product Specification
| Host | Rabbit |
| Antigen | EGFR |
| Synonyms | Epidermal growth factor receptor, ERBB1, HER1, c-ErbB-1 |
| Immunogen | N/A |
| Location | Endosome, Cell membrane, Endoplasmic reticulum membrane, Golgi apparatus membrane |
| Accession | P00533 |
| Clone Number | SDT-R110 |
| Antibody Type | Rabbit mAb |
| Application | WB, IHC-P, ICC |
| Reactivity | Hu, Ms, Rt |
| Purification | Protein A |
| Concentration | 0.5 mg/ml |
| Physical Appearance | Liquid |
| Storage Buffer | PBS, 40% Glycerol, 0.05% BSA, 0.03% Proclin 300 |
| Stability & Storage | 12 months from date of receipt / reconstitution, -20 °C as supplied |
Dilution
| application | dilution | species |
| WB | 1:1000 | null |
| IHC-P | 1:500-1:2000 | null |
| ICC | 1:500 | null |
Background
The epidermal growth factor receptor (EGFR) is a growth factor receptor that induces cell differentiation and proliferation upon activation through the binding of one of its ligands. The receptor is located at the cell surface, where the binding of a ligand activates a tyrosine kinase in the intracellular region of the receptor. This tyrosine kinase phosphorylates a number of intracellular substrates that activates pathways leading to cell growth, DNA synthesis and the expression of oncogenes such fos and jun [PMID: 9496384].
Picture
Picture
Western Blot

Immunohistochemistry

IHC shows positive staining in paraffin-embedded human colon. Anti-EGFR antibody was used at 1/2000 dilution, followed by a HRP Polymer for Mouse & Rabbit IgG (ready to use). Counterstained with hematoxylin. Heat mediated antigen retrieval with Tris/EDTA buffer pH9.0 was performed before commencing with IHC staining protocol.

IHC shows positive staining in paraffin-embedded human esophagus. Anti-EGFR antibody was used at 1/2000 dilution, followed by a HRP Polymer for Mouse & Rabbit IgG (ready to use). Counterstained with hematoxylin. Heat mediated antigen retrieval with Tris/EDTA buffer pH9.0 was performed before commencing with IHC staining protocol.

IHC shows positive staining in paraffin-embedded human placenta. Anti-EGFR antibody was used at 1/2000 dilution, followed by a HRP Polymer for Mouse & Rabbit IgG (ready to use). Counterstained with hematoxylin. Heat mediated antigen retrieval with Tris/EDTA buffer pH9.0 was performed before commencing with IHC staining protocol.

IHC shows positive staining in paraffin-embedded human skin. Anti-EGFR antibody was used at 1/2000 dilution, followed by a HRP Polymer for Mouse & Rabbit IgG (ready to use). Counterstained with hematoxylin. Heat mediated antigen retrieval with Tris/EDTA buffer pH9.0 was performed before commencing with IHC staining protocol.

IHC shows positive staining in paraffin-embedded human tonsil. Anti-EGFR antibody was used at 1/2000 dilution, followed by a HRP Polymer for Mouse & Rabbit IgG (ready to use). Counterstained with hematoxylin. Heat mediated antigen retrieval with Tris/EDTA buffer pH9.0 was performed before commencing with IHC staining protocol.

IHC shows positive staining in paraffin-embedded human endometrial cancer. Anti-EGFR antibody was used at 1/2000 dilution, followed by a HRP Polymer for Mouse & Rabbit IgG (ready to use). Counterstained with hematoxylin. Heat mediated antigen retrieval with Tris/EDTA buffer pH9.0 was performed before commencing with IHC staining protocol.

IHC shows positive staining in paraffin-embedded human cervical squamous cell carcinoma. Anti-EGFR antibody was used at 1/2000 dilution, followed by a HRP Polymer for Mouse & Rabbit IgG (ready to use). Counterstained with hematoxylin. Heat mediated antigen retrieval with Tris/EDTA buffer pH9.0 was performed before commencing with IHC staining protocol.

IHC shows positive staining in paraffin-embedded human lung squamous cell carcinoma. Anti-EGFR antibody was used at 1/2000 dilution, followed by a HRP Polymer for Mouse & Rabbit IgG (ready to use). Counterstained with hematoxylin. Heat mediated antigen retrieval with Tris/EDTA buffer pH9.0 was performed before commencing with IHC staining protocol.

IHC shows positive staining in paraffin-embedded human lung adenocarcinoma. Anti-EGFR antibody was used at 1/2000 dilution, followed by a HRP Polymer for Mouse & Rabbit IgG (ready to use). Counterstained with hematoxylin. Heat mediated antigen retrieval with Tris/EDTA buffer pH9.0 was performed before commencing with IHC staining protocol.

IHC shows positive staining in paraffin-embedded human hepatocellular carcinoma. Anti-EGFR antibody was used at 1/2000 dilution, followed by a HRP Polymer for Mouse & Rabbit IgG (ready to use). Counterstained with hematoxylin. Heat mediated antigen retrieval with Tris/EDTA buffer pH9.0 was performed before commencing with IHC staining protocol.

IHC shows positive staining in paraffin-embedded mouse colon. Anti-EGFR antibody was used at 1/500 dilution, followed by a HRP Polymer for Mouse & Rabbit IgG (ready to use). Counterstained with hematoxylin. Heat mediated antigen retrieval with Tris/EDTA buffer pH9.0 was performed before commencing with IHC staining protocol.

IHC shows positive staining in paraffin-embedded rat stomach. Anti-EGFR antibody was used at 1/500 dilution, followed by a HRP Polymer for Mouse & Rabbit IgG (ready to use). Counterstained with hematoxylin. Heat mediated antigen retrieval with Tris/EDTA buffer pH9.0 was performed before commencing with IHC staining protocol.
Immunocytochemistry

ICC shows positive staining in A431 cells. Anti-EGFR antibody was used at 1/500 dilution (Green) and incubated overnight at 4°C. Goat polyclonal Antibody to Rabbit IgG - H&L (Alexa Fluor® 488) was used as secondary antibody at 1/1000 dilution. The cells were fixed with 4% PFA and permeabilized with 0.1% PBS-Triton X-100. Nuclei were counterstained with DAPI (Blue).